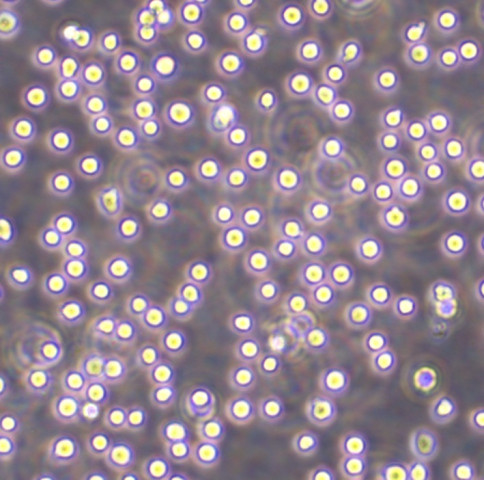
Akata CellsEBV转化淋巴悬浮细胞系(提供全部细胞STR鉴定图谱)

"Akata CellsEBV转化淋巴悬浮细胞系(提供全部细胞STR鉴定图谱)
传代比例:1:2-1:4(首次传代建议1:2)
背景信息:详见相关文献介绍
┈订┈购(技术服务)┈热┈线:1┈3┈6┈4┈1┈9┈3┈0┈7┈9┈1【微信同号】┈Q┈Q:3┈1┈8┈0┈8┈0┈7┈3┈2┈4;
L-cells Cells;背景说明:详见相关文献介绍;传代方法:1:2-1:3传代;每周换液2-3次。;生长特性:贴壁或悬浮,详见产品说明书部分;形态特性:详见产品说明书;相关产品有:UPCI-SCC-090细胞、HCT 116细胞、Hopkins-92细胞
SW 48 Cells;背景说明:1971-1975年间,A. Leibovitz从结肠腺癌中分离建立十个细胞系,SW48为为其中之一。该细胞合成癌胚抗原,能在裸鼠中成瘤。;传代方法:1:3传代,2-3天传一代;生长特性:贴壁生长;形态特性:上皮细胞样;相关产品有:HCe-8693细胞、MFHL-2细胞、Detroit-562细胞
MHCC97L Cells;背景说明:来源于中山医院,生长较缓慢;传代方法:1:2传代;生长特性:贴壁生长;形态特性:上皮样;相关产品有:MESSADX5细胞、COLO 741细胞、CEM-C7细胞
JS1 Cells;背景说明:肝星形 Cells;传代方法:1:2-1:3传代;每周换液2-3次。;生长特性:贴壁;形态特性:详见产品说明书;相关产品有:786-O RCC细胞、GM07404A细胞、CHP-126细胞
换液周期:每周2-3次
常见细胞培养中一些问题总结:1)培养基中血清的比例多少合适?血清是细胞培养上一个为重要的营养来源,所以血清的含量多少会对细胞的生长会产生大的影响。血清的含量一般为5%-15%,不要低于5%或GAO过20%,因为含量过低会导致细胞营养不足,过GAO则会破坏渗透压平衡。一般建议血清含量为10%,可以适量加减;2)何时须更换培养基?视细胞生长密度而定,或遵照细胞株基本数据上的更换时间,按时更换培养基即可。还可以参照指示剂的颜色变化进行更换;3)购买的复苏细胞,为何会有脱落?因为运输的过程中不可避免的会有震荡,收到后可以离心收集;4)购买的细胞冷冻管经解冻后,为何会发生细胞数目太少之情形?研究人员在冷冻细胞之培养时出现细胞数目太少,大都是因为离心过程操作上的失误,造成细胞的物理性损伤,以及细胞流失。建议细胞解冻后不要立刻离心,应待细胞生长隔夜后再更换培养基即可;5)购买的细胞死亡或细胞存活率不佳可能原因?研究人员在细胞培养时出现存活率不佳,常见原因可归纳为:培养基使用错误或培养基品质不佳。血清使用错误或血清的品质不佳。解冻过程错误。冷冻细胞解冻后,加以洗涤细胞和离心。悬浮细胞误认为死细胞。培养温度使用错误。细胞置于–80°C太久;6)收到的冷冻管瓶身破裂,瓶盖有裂纹,或瓶盖脱落之原因?冷冻管瓶盖裂纹,或瓶身破裂,可能是因为操作者夹取冷冻管时用力不当,造成冷冻管裂损,建议使用止血钳小心夹取。另冷冻管瓶盖松动或松脱,乃因热胀冷缩之物理现象,冷冻管有可能因此而造成细胞污染,故冷冻管于放入和取出桶时,均应立刻将冷冻管再一次扭紧。
Akata CellsEBV转化淋巴悬浮细胞系(提供全部细胞STR鉴定图谱)
生长特性:悬浮生长
产品包装:复苏发货:T25培养瓶(一瓶)或冻存发货:1ml冻存管(两支)
RPMI-8226 Cells;背景说明:来源于一位61岁的男性浆细胞瘤患者;可产生免疫球蛋白轻链,未检测到重链。;传代方法:按1:2传代,5-6小时可以看到细胞分裂;生长特性:悬浮生长;形态特性:淋巴母细胞样;相关产品有:Human Epithelioma-2细胞、CCRF-CEM细胞、Turbot Embryonic Cell line细胞
LAN-6 Cells;背景说明:详见相关文献介绍;传代方法:1:2-1:3传代;每周换液2-3次。;生长特性:贴壁或悬浮,详见产品说明书部分;形态特性:详见产品说明书;相关产品有:H82sclc细胞、207细胞、CFPAC细胞
CACO2 Cells;背景说明:细胞株分离自一个原发性结肠癌。当细胞长满时,表现出典型的肠细胞分化的特征。Caco-2细胞表达维生素A酸结合蛋白I和视黄醇结合蛋白II,角蛋白阳性。;传代方法:1:2-1:3传代;每周换液2-3次。;生长特性:贴壁;形态特性:上皮细胞样;相关产品有:PCI:SG231细胞、HFB细胞、GBCSD细胞
RBL Cells;背景说明:详见相关文献介绍;传代方法:1:2-1:3传代;每周换液2-3次。;生长特性:贴壁或悬浮,详见产品说明书部分;形态特性:详见产品说明书;相关产品有:MMAc.SF细胞、NK92MI细胞、H747细胞
┈订┈购(技术服务)┈热┈线:1┈3┈6┈4┈1┈9┈3┈0┈7┈9┈1【微信同号】┈Q┈Q:3┈1┈8┈0┈8┈0┈7┈3┈2┈4;
来源说明:细胞主要来源ATCC、ECACC、DSMZ、RIKEN等细胞库
【细胞培养中支原体、黑蛟虫、真菌的污染情况总结】支原体:黑色的,HAO象多为多形,培养一般培养一般会浑浊,原体感染,国内血清很多都没有做支原体阴性检测,而支原体是牛血清中Zui常见的微生物之一。而且它不能用过滤的办法除去。支原体感染细胞以后,细胞病变不很明显,只是慢慢死去。用泰乐菌素,兽用支原体病的药,但可用于细胞培养,无任何不良反应。如果作为常用的抗生素的话, 建议用8ug/ml的浓度;黑蛟虫:可以穿透滤膜,也可以通过空气传播,低倍下为黑色点状,GAO倍下可看见黑色的小虫游来游去,培养也是不浑的,一般不会太影响,细胞还是可以用的。常常是细胞生长状态良HAO,且观测到的运动物无明显增多,且培养颜色、透明度无明显变化,可在同一批号的血清养的细胞中发现类似现象。对细胞生长状态不会有明显影响,在细胞增殖旺盛之后会自然消失,除更换血清外无须殊处理。建议如果细胞有可能是此种污染的话,可以增加细胞的种板密度,以提GAO细胞的生存率;真菌:一般培养清亮,不变色,镜下有丝状物,有些真菌开始很像死细胞碎片,只是它很多很多的小块很清楚,象珊瑚状,不象细胞碎片分不清,慢慢的会长出很细的黑色丝状物。真菌生长的比较慢,不象细菌那么容易被发现,但是一旦发现有它的存在细胞就被污染了,也很难救活了。
物种来源:人源、鼠源等其它物种来源
Akata CellsEBV转化淋巴悬浮细胞系(提供全部细胞STR鉴定图谱)
形态特性:淋巴母细胞样
在实验室细胞培养过程中,细胞聚集是一个常见的问题,它可能会影响细胞的正常生长、实验结果的准确性等诸多方面。为了防止细胞聚集,科研人员通常会采用多种有效的方法。首先,合适的细胞培养容器表面处理至关重要。许多细胞培养瓶和培养皿会经过特殊的表面处理,例如用亲水性的聚合物涂层。减少细胞之间因为吸附在同一位置而聚集的可能性。酶处理也是常用的手段之一。在细胞消化传代过程中,使用适量的胰蛋白酶等酶试剂。胰蛋白酶能够分解细胞间的连接蛋白,使细胞彼此分离。但是,酶的浓度和处理时间需要严格把控。如果酶浓度过高或者处理时间过长,虽然细胞能够很好地分散,但可能会对细胞造成损伤,影响细胞的活性。以常见的哺乳动物细胞为例,一般使用0.25%的胰蛋白酶,在37℃下处理1-3分钟,就可以有效地将细胞分散开,同时又能保证细胞的健康状态。添加合适的试剂也是防止细胞聚集的有效策略。一些抗聚集剂如乙二胺四乙酸(EDTA)被广泛使用。EDTA能够螯合细胞培养液中的钙、镁离子,而这些离子是细胞间连接所依赖的重要成分。当它们被螯合后,细胞间的连接就会变弱,从而减少聚集。在细胞培养过程中,轻柔的操作也不容忽视。无论是在细胞的接种、换液还是转移过程中,避免剧烈摇晃或吹打。通过这些综合的方法,实验室能够更好地防止细胞聚集,为细胞系培养实验的成功提供保障。
297A1 Cells(提供STR鉴定图谱)
Abcam HeLa SFN KO Cells(提供STR鉴定图谱)
AG24458 Cells(提供STR鉴定图谱)
BayGenomics ES cell line RRI274 Cells(提供STR鉴定图谱)
BayGenomics ES cell line XH746 Cells(提供STR鉴定图谱)
C2095 Cells(提供STR鉴定图谱)
DA00091 Cells(提供STR鉴定图谱)
DA05541 Cells(提供STR鉴定图谱)
GH3 Cells(提供STR鉴定图谱)
1E8-H Cells;背景说明:前列腺癌;男性;传代方法:1:2-1:3传代;每周换液2-3次。;生长特性:贴壁;形态特性:详见产品说明书;相关产品有:RPMI 7666细胞、RBSMC细胞、LNCaP细胞
CCRF SB Cells;背景说明:急性T淋巴细胞白血病;男性;传代方法:1:2-1:3传代;每周换液2-3次。;生长特性:悬浮;形态特性:详见产品说明书;相关产品有:H-1355细胞、KTCTL-140细胞、A101D细胞
K422 Cells;背景说明:详见相关文献介绍;传代方法:1:2-1:3传代;每周换液2-3次。;生长特性:贴壁或悬浮,详见产品说明书部分;形态特性:详见产品说明书;相关产品有:N2a细胞、DHL-8细胞、Chang Cells细胞
EM3 Cells;背景说明:髓系白血病;女性;传代方法:1:2-1:3传代;每周换液2-3次。;生长特性:悬浮;形态特性:详见产品说明书;相关产品有:WISH细胞、BRL3A细胞、Mino细胞
H292 Cells;背景说明:详见相关文献介绍;传代方法:1:3-1:8传代;2-3天换液1次。;生长特性:贴壁生长;形态特性:上皮样;相关产品有:SNU620细胞、BALB/3T3 clone A31细胞、NCI-H157细胞
HCC1954-BL Cells;背景说明:外周血B淋巴细胞;EBV转化;女性;传代方法:1:2-1:3传代;每周换液2-3次。;生长特性:悬浮;形态特性:详见产品说明书;相关产品有:HEK-A细胞、SK-MEL-3细胞、MyLa 2059细胞
MDA-MB-175 Cells;背景说明:该细胞源自一位54岁患有乳腺导管癌白人女性的胸腔积液。;传代方法:1:2—1:6传代,每周换液2—3次;生长特性:松散贴壁生长;形态特性:上皮细胞样;相关产品有:293T/17细胞、MDA-MB-453细胞、UCH-1细胞
Cloudman S91 melanoma Cells;背景说明:黑色素瘤;雄性;DBA;传代方法:1:2-1:3传代;每周换液2-3次。;生长特性:贴壁;形态特性:详见产品说明书;相关产品有:COLO 206细胞、CAL39细胞、NCI-522细胞
COLO-320-DM Cells;背景说明:该细胞可产生5-羟色胺、去甲、、ACTH和甲状旁腺素。角蛋白、波形蛋白弱阳性。培养条件: RPMI 1640 10%FBS;传代方法:1:2-1:3传代;每周换液2-3次。;生长特性:悬浮+贴壁;形态特性:淋巴细胞;相关产品有:GEO细胞、KYSE-520细胞、SW1353细胞
HCC 70 Cells;背景说明:详见相关文献介绍;传代方法:1:4-1:6传代;每周换液2-3次。;生长特性:贴壁生长;形态特性:上皮样;相关产品有:Nthy-ori 3-1细胞、SK-MEL28细胞、AC16 [Human hybrid]细胞
NCI-H2073 Cells;背景说明:详见相关文献介绍;传代方法:1:3-1:6传代 ;生长特性:贴壁生长;形态特性:上皮细胞;相关产品有:Gerner 7666细胞、HS-68细胞、B35细胞
HCT-FET Cells;背景说明:结肠癌;传代方法:1:2-1:3传代;每周换液2-3次。;生长特性:贴壁;形态特性:详见产品说明书;相关产品有:KYSE 50细胞、H3255细胞、HCT-8细胞
MS-751 Cells;背景说明:这株细胞是J. Sykes于1974年建立的(参考ATCC HTB-33)。有报告称MS751细胞含有人乳头状瘤病毒18 (HPV-18)序列。[22995] [23180]后来发现MS751细胞包含HPV-45基因组的一部分,而其中E6/E7区域表达呈poly(A)+RNA的形式。[49721];传代方法:1:2传代;生长特性:贴壁生长;形态特性:上皮细胞样;相关产品有:H-1184细胞、COLO.205细胞、H847细胞
LMTK- Cells;背景说明:详见相关文献介绍;传代方法:1:2-1:3传代;每周换液2-3次。;生长特性:贴壁或悬浮,详见产品说明书部分;形态特性:详见产品说明书;相关产品有:ECV细胞、MUM2B细胞、MOLM-13细胞
Factor Dependent Continuous-Paterson 1 Cells;背景说明:详见相关文献介绍;传代方法:2-3天换液1次;生长特性:悬浮生长;形态特性:淋巴母细胞;相关产品有:Capan-1细胞、HIT.T15细胞、MB 157细胞
Ramos 2G6.4C10 Cells;背景说明:详见相关文献介绍;传代方法: 维持细胞浓度在2×105/ml-1×106/ml;根据细胞浓度每2-3天补液1次。;生长特性:悬浮生长 ;形态特性:淋巴母细胞样;相关产品有:NSI/1-Ag4-1细胞、Hx147细胞、no.11细胞
Ramos 2G6.4C10 Cells;背景说明:详见相关文献介绍;传代方法: 维持细胞浓度在2×105/ml-1×106/ml;根据细胞浓度每2-3天补液1次。;生长特性:悬浮生长 ;形态特性:淋巴母细胞样;相关产品有:NSI/1-Ag4-1细胞、Hx147细胞、no.11细胞
Akata CellsEBV转化淋巴悬浮细胞系(提供全部细胞STR鉴定图谱)
MHCCLM3 Cells;背景说明:详见相关文献介绍;传代方法:1:2传代;生长特性:贴壁生长;形态特性:上皮样;相关产品有:HCC0095细胞、H2110细胞、SNU-719细胞
SW 1783 Cells;背景说明:间变性星形细胞瘤;男性;传代方法:1:2-1:3传代;每周换液2-3次。;生长特性:贴壁;形态特性:详见产品说明书;相关产品有:BEL7404细胞、P-388细胞、LTPA细胞
SW 780 Cells;背景说明:详见相关文献介绍;传代方法:1:2-1:3传代;每周换液2-3次。;生长特性:贴壁或悬浮,详见产品说明书部分;形态特性:详见产品说明书;相关产品有:Hs-695-T细胞、H82sclc细胞、H-1734细胞
MDA.MB.435 Cells;背景说明:乳腺癌;传代方法:1:2-1:3传代;每周换液2-3次。;生长特性:贴壁;形态特性:详见产品说明书;相关产品有:B-cell with DC Morphology细胞、PCI-4.2细胞、Liver-02细胞
LCLC-103H Cells;背景说明:详见相关文献介绍;传代方法:1:2-1:3传代;每周换液2-3次。;生长特性:贴壁或悬浮,详见产品说明书部分;形态特性:详见产品说明书;相关产品有:Mouse Forestomach Carcinoma细胞、RPMI 7666细胞、PA-TU-8988S细胞
CCRF/CEM-C7 Cells;背景说明:急性T淋巴细胞白血病;女性;传代方法:1:2-1:3传代;每周换液2-3次。;生长特性:悬浮;形态特性:详见产品说明书;相关产品有:SLMT-1细胞、COLO206细胞、SCCVII/St细胞
┈订┈购(技术服务)┈热┈线:1┈3┈6┈4┈1┈9┈3┈0┈7┈9┈1【微信同号】┈Q┈Q:3┈1┈8┈0┈8┈0┈7┈3┈2┈4;
MCA 38 Cells;背景说明:详见相关文献介绍;传代方法:1:2传代;生长特性:贴壁生长;形态特性:上皮细胞样;相关产品有:MeSoTheliOma-211H细胞、NSI/1-Ag4-1细胞、GC-1spg细胞
Walker/LLC-WRC 256 Cells;背景说明:乳腺癌;雌性;传代方法:1:2-1:3传代;每周换液2-3次。;生长特性:贴壁;形态特性:详见产品说明书;相关产品有:GM05384细胞、Panc8.13细胞、HCT 8细胞
SKLMS-1 Cells;背景说明:详见相关文献介绍;传代方法:1:2-1:5传代,2-3天换液1次。;生长特性:贴壁生长;形态特性:成纤维细胞;相关产品有:NTERA2D1细胞、ASPC1细胞、16-HBE14o细胞
McCoy B Cells;背景说明:成纤维 Cells;传代方法:1:2-1:3传代;每周换液2-3次。;生长特性:贴壁;形态特性:详见产品说明书;相关产品有:SNU16细胞、NCIH1373细胞、BEL-7405细胞
HEP-3B2 Cells;背景说明:肝癌;男性;传代方法:1:2-1:3传代;每周换液2-3次。;生长特性:贴壁;形态特性:详见产品说明书;相关产品有:CNE-2Z细胞、OCLY8细胞、KMM-1细胞
Hs 822.T Cells;背景说明:详见相关文献介绍;传代方法:1:2-1:4传代;每周换液2-3次。;生长特性:贴壁生长;形态特性:上皮样;相关产品有:SK-N-MC细胞、CV 1细胞、GCT0404细胞
GM11477 Cells(提供STR鉴定图谱)
HAP1 CTTN (-) 4 Cells(提供STR鉴定图谱)
HAP1 TWIST1 (-) Cells(提供STR鉴定图谱)
HGMDFN090 Cells(提供STR鉴定图谱)
INSAi002-A Cells(提供STR鉴定图谱)
M229 R5 Cells(提供STR鉴定图谱)
ND06087 Cells(提供STR鉴定图谱)
PENN112i-304-6 Cells(提供STR鉴定图谱)
SDUe002-A Cells(提供STR鉴定图谱)
U-937 RERC Cells(提供STR鉴定图谱)
UM4-13 Cells(提供STR鉴定图谱)
1H11 [Mouse hybridoma against M.marinum 56 kDa antigen] Cells(提供STR鉴定图谱)
143 B Cells;背景说明:详见相关文献介绍;传代方法:1:2—1:5传代;每周换液2-3次;生长特性:贴壁生长;形态特性:混合型;相关产品有:NCI-SNU-407细胞、ARO-81细胞、SKM-1细胞
TOV-112D Cells;背景说明:详见相关文献介绍;传代方法:1:2-1:3传代,3-4天换液1次。;生长特性:贴壁生长;形态特性:上皮细胞;相关产品有:ECGI10细胞、HEK293-H细胞、Hs68细胞
Astrocyte type I clone Cells;背景说明:该永生化细胞系源自出生8天小鼠小脑组织,由B Pessac, D Trisler建立。该细胞具有小神经胶质细胞特征。该细胞为GFAP阳性细胞,除此之外,没有检测到其它神经胶质神经元或小神经胶质细胞的分子标记。;传代方法:1:2传代;生长特性:贴壁生长 ;形态特性:详见产品说明书;相关产品有:NCI-SNU-1细胞、H2.35细胞、SHI1细胞
TE-3A Cells;背景说明:详见相关文献介绍;传代方法:1:2-1:3传代;每周换液2-3次。;生长特性:贴壁或悬浮,详见产品说明书部分;形态特性:详见产品说明书;相关产品有:COLO 741细胞、GM06141B细胞、SuperTube细胞
HEK-293-F Cells;背景说明:详见相关文献介绍;传代方法:1:2传代;生长特性:贴壁生长;悬浮生长;形态特性:上皮细胞样;相关产品有:201T细胞、NCI-H1048细胞、STO细胞
CPA47 Cells;背景说明:肺血管;内皮 Cells;传代方法:1:2-1:3传代;每周换液2-3次。;生长特性:贴壁;形态特性:详见产品说明书;相关产品有:C3H10T1/2细胞、U251-MG细胞、AR4IP细胞
OCM1 Cells;背景说明:葡萄膜黑色素瘤;女性;传代方法:1:2-1:3传代;每周换液2-3次。;生长特性:贴壁;形态特性:详见产品说明书;相关产品有:CTV-1细胞、hTERTHME1细胞、CL-11细胞
FU-MMT-1 Cells;背景说明:子宫肉瘤;女性;传代方法:1:2-1:3传代;每周换液2-3次。;生长特性:贴壁;形态特性:详见产品说明书;相关产品有:KG-1a细胞、H-522细胞、SK-Mel 2细胞
MNNGHOS Cells;背景说明:骨肉瘤;女性;传代方法:1:2-1:3传代;每周换液2-3次。;生长特性:贴壁;形态特性:详见产品说明书;相关产品有:BIC1细胞、V 79细胞、H28细胞
OCI-AML2 Cells;背景说明:急性髓系白血病;男性;传代方法:1:2-1:3传代;每周换液2-3次。;生长特性:悬浮;形态特性:详见产品说明书;相关产品有:COLO320DM细胞、Panc02.03细胞、HNE1细胞
NCI-H2106 Cells;背景说明:详见相关文献介绍;传代方法:每周换液2次。;生长特性:悬浮生长;形态特性:详见产品说明书;相关产品有:Institute for Medical Research-32细胞、SK-OV-433细胞、VMM-5A细胞
G401 Cells;背景说明:详见相关文献介绍;传代方法:1:2-1:6传代,每周2-3次。;生长特性:贴壁生长;形态特性:上皮细胞样;相关产品有:PaTu-8988s细胞、GM03571细胞、H322细胞
A-172 MG Cells;背景说明:详见相关文献介绍;传代方法:1:2-1:3传代;每周换液2-3次。;生长特性:贴壁或悬浮,详见产品说明书部分;形态特性:详见产品说明书;相关产品有:HCC-827细胞、COLO-824细胞、MEC1细胞
C-6 Cells;背景说明:胶质细胞株C6是由Benda等用N-nitrosomethylurea诱导的大鼠胶质瘤克隆,并经过一系列的体外培养和动物传代交替后建成的。 当细胞从低密度生长到满瓶时,S-100产量增加10倍。;传代方法:1:2传代;生长特性:贴壁生长;形态特性:上皮细胞样;相关产品有:MRC9细胞、JIMT细胞、GM-637细胞
MFE-296 Cells;背景说明:详见相关文献介绍;传代方法:1:2传代;生长特性:贴壁生长;形态特性:详见产品说明书;相关产品有:PIG1细胞、H-747细胞、A375mel细胞
HEL9217 Cells;背景说明:详见相关文献介绍;传代方法:每周2-3次。;生长特性:悬浮生长;形态特性:成淋巴细胞;相关产品有:Kato-III细胞、H1836细胞、TE 85.T细胞
CCFSTTG1 Cells;背景说明:详见相关文献介绍;传代方法:1:3—1:6传代;每周换液2-3次;生长特性:贴壁生长;形态特性:星形胶质细胞;相关产品有:CORL105细胞、HSAEC1-KT细胞、HCC2279细胞
COR-L23/P Cells;背景说明:详见相关文献介绍;传代方法:1:2-1:3传代;每周换液2-3次。;生长特性:贴壁或悬浮,详见产品说明书部分;形态特性:详见产品说明书;相关产品有:RKO-E6细胞、AtT 20细胞、NALM-6细胞
COLO-320 Cells;背景说明:详见相关文献介绍;传代方法:1:2-1:3传代;每周换液2-3次。;生长特性:贴壁;形态特性:淋巴母细胞;相关产品有:AML-12细胞、LLCMK2细胞、SSP-25细胞
COLO-320 Cells;背景说明:详见相关文献介绍;传代方法:1:2-1:3传代;每周换液2-3次。;生长特性:贴壁;形态特性:淋巴母细胞;相关产品有:AML-12细胞、LLCMK2细胞、SSP-25细胞
U-251 Cells;背景说明:U-251 MG分离至一位患者的胶质母细胞瘤组织。;传代方法:1:2-1:3传代;每周换液2-3次。;生长特性:贴壁;形态特性:成纤维细胞样;相关产品有:Hs 606细胞、293E细胞、CT26-clone 25细胞
SW839 Cells;背景说明:详见相关文献介绍;传代方法:1:2传代;生长特性:贴壁生长 ;形态特性:详见产品说明书;相关产品有:RC-2细胞、Kit 225 K6细胞、SNU182细胞
OCI-Ly8 Cells;背景说明:弥漫大B淋巴瘤;传代方法:1:2-1:3传代;每周换液2-3次。;生长特性:悬浮;形态特性:详见产品说明书;相关产品有:FRTL5细胞、LCMS细胞、NCI-H69细胞
Panc 05.04 Cells;背景说明:详见相关文献介绍;传代方法:1:2传代;生长特性:贴壁生长;形态特性:上皮样;相关产品有:KMST6细胞、CMEC/D3细胞、NUGC-4细胞
N-Tera-2 Cells;背景说明:畸胎瘤;男性;传代方法:1:2-1:3传代;每周换液2-3次。;生长特性:贴壁;形态特性:详见产品说明书;相关产品有:RBL-2H3细胞、IEC 18细胞、PC-3M IE8细胞
Anip973 Cells;背景说明:肺腺癌;传代方法:1:2-1:3传代;每周换液2-3次。;生长特性:贴壁;形态特性:详见产品说明书;相关产品有:WI-38细胞、COLO-320-DM细胞、MDCKII细胞
EFM192B Cells;背景说明:详见相关文献介绍;传代方法:1:2-1:3传代;每周换液2-3次。;生长特性:贴壁或悬浮,详见产品说明书部分;形态特性:详见产品说明书;相关产品有:COLO-394细胞、NCI-H2227细胞、Helacyton gartleri细胞
Akata CellsEBV转化淋巴悬浮细胞系(提供全部细胞STR鉴定图谱)
SK_N_BE2C Cells;背景说明:神经母细胞瘤;骨髓转移;男性;传代方法:1:2-1:3传代;每周换液2-3次。;生长特性:贴壁;形态特性:详见产品说明书;相关产品有:MSTO-211 H细胞、NCI-H865细胞、NCIH2126细胞
PK-136 Cells;背景说明:详见相关文献介绍;传代方法:1:2-1:3传代;每周换液2-3次。;生长特性:贴壁或悬浮,详见产品说明书部分;形态特性:详见产品说明书;相关产品有:NCI-H1876细胞、NCI-H295细胞、DHL-8细胞
TE 32 Cells;背景说明:详见相关文献介绍;传代方法:1:2-1:4传代,3-4天换液1次。;生长特性:贴壁生长;形态特性:梭型和大的多核细胞;相关产品有:Pro-5 Lec1.3c细胞、T-ALL 1细胞、NCI-H23细胞
SUM 190PT Cells;背景说明:乳腺癌;女性;传代方法:1:2-1:3传代;每周换液2-3次。;生长特性:贴壁;形态特性:详见产品说明书;相关产品有:LS174T细胞、HeLaS3细胞、NE-1细胞
ATN1 Cells;背景说明:详见相关文献介绍;传代方法:1:2-1:3传代;每周换液2-3次。;生长特性:贴壁或悬浮,详见产品说明书部分;形态特性:详见产品说明书;相关产品有:NOR 10细胞、GM-215细胞、H-727细胞
CEM Cells;背景说明:G.E. Foley 等人建立了类淋巴母细胞细胞株CCRF-CEM。 细胞是1964年11月从一位四岁白人女性急性淋巴细胞白血病患者的外周血白血球衣中得到。此细胞系从香港收集而来。;传代方法:1:2传代。3天内可长满。;生长特性:悬浮生长;形态特性:淋巴母细胞样;相关产品有:Stanford University-Diffuse Histiocytic Lymphoma-4细胞、HEK-293H细胞、H740细胞
Hs 766 Cells;背景说明:详见相关文献介绍;传代方法:1:2—1:8传代,每周换液2—3次;生长特性:贴壁生长;形态特性:上皮细胞;相关产品有:SUM52PE细胞、U266-B1细胞、MEF细胞
SkChA1 Cells;背景说明:详见相关文献介绍;传代方法:1:2-1:3传代;每周换液2-3次。;生长特性:贴壁或悬浮,详见产品说明书部分;形态特性:详见产品说明书;相关产品有:REC1细胞、TK-1细胞、U-2-OS细胞
┈订┈购(技术服务)┈热┈线:1┈3┈6┈4┈1┈9┈3┈0┈7┈9┈1【微信同号】┈Q┈Q:3┈1┈8┈0┈8┈0┈7┈3┈2┈4;
H-1954 Cells;背景说明:详见相关文献介绍;传代方法:1:2-1:3传代;每周换液2-3次。;生长特性:贴壁或悬浮,详见产品说明书部分;形态特性:详见产品说明书;相关产品有:OV 1063细胞、Functional Liver Cell-7细胞、Hs 766T细胞
CHO-K1 Cells;背景说明:1957年,PuckTT从成年中国仓鼠卵巢的活检组织建立了CHO细胞,CHO-K1是CHO的一个亚克隆。CHO-K1的生长需要脯酸。;传代方法:1:2传代;生长特性:贴壁生长;形态特性:上皮样;相关产品有:L-6细胞、ZR75-30细胞、T2细胞
Hs 888Lu Cells;背景说明:详见相关文献介绍;传代方法:1:2传代;生长特性:贴壁生长 ;形态特性:详见产品说明书;相关产品有:SW 579细胞、NCI-H1341细胞、G-402细胞
BayGenomics ES cell line CSH949 Cells(提供STR鉴定图谱)
BayGenomics ES cell line RST188 Cells(提供STR鉴定图谱)
BsB7 Cells(提供STR鉴定图谱)
L1Mab-13 Cells(提供STR鉴定图谱)
PRCA157 Cells(提供STR鉴定图谱)
Rat-1/T7-Cdt1 WB4 Cells(提供STR鉴定图谱)
"